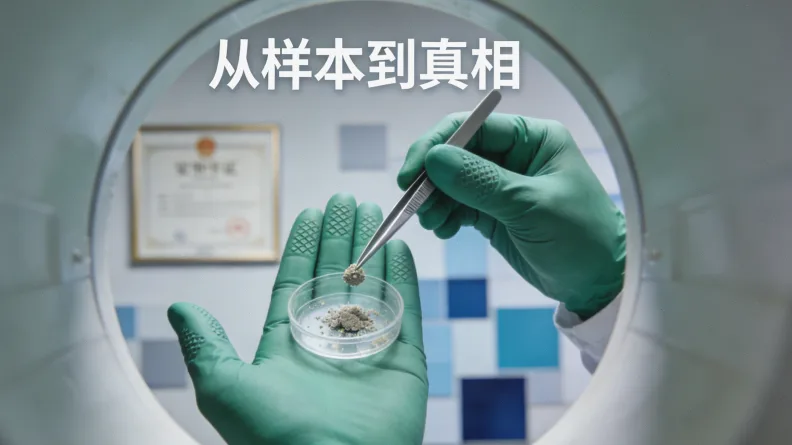
不同基因检测技术方法对比示意图

摘要: 很多肺癌患者和家属都在问:MET检测,医保能报销吗?这篇文章就像朋友聊天一样,给你讲清楚报销的门道。咱们会聊聊MET检测为什么重要,报销到底看哪几个硬性条件,自费大概要花多少钱,以及你该怎么和医生沟通这件事。看完你就心里有数了。
开头咱们聊聊:MET检测和医保报销,到底是怎么回事?
直接说重点吧,今天咱们就聊一个非常实际的问题:MET检测,医保能报销吗? 这不是一个简单的“能”或“不能”就能回答的。对于很多非小细胞肺癌患者来说,MET基因的状态直接决定了能不能用上靶向药,这是救命的关键一步。但检测费用不低,医保能不能分担一部分,就成了大家最揪心的事。别急,咱们把这里面的弯弯绕绕,掰开揉碎了说清楚。
MET检测是什么?为什么它对肺癌治疗这么关键?

你可以把MET基因想象成细胞上的一把“钥匙孔”。正常情况下,它接收信号,指挥细胞有序生长。可一旦这个基因出了问题,比如过度活跃(扩增)或者锁孔形状变了(突变),它就会变成一把“坏锁”,不停地给细胞发疯长信号,最终导致癌症。
特别是在非小细胞肺癌里,MET基因的异常(比如14号外显子跳跃突变)已经是一个明确的治疗靶点。这意味着,如果检测出有这个突变,患者就有机会使用像赛沃替尼、谷美替尼这类专门的靶向药,效果可能比化疗好,副作用也相对更轻。所以,做MET检测,根本目的是为了找到最适合你的那把“钥匙”(药物),实现精准打击。这是现代肿瘤个体化治疗的基石。
医保能报销MET检测吗?关键看这3个条件!

好了,回到最核心的问题:MET检测,医保能报销吗? 答案是:有可能,但必须同时满足几个硬性条件,缺一不可。
第一个条件,也是最重要的:你的病情必须符合医保规定的“适应症”。 国家医保目录可不是随便覆盖的。通常,只有被临床指南明确推荐、用于指导特定靶向药物治疗的基因检测,才有可能被纳入报销范围。对于MET检测,目前主要针对的是“晚期非小细胞肺癌患者,需要明确是否存在MET exon14跳跃突变以指导靶向治疗”这个场景。如果你是早期患者,或者是为了术后监测等其他目的做检测,医保大概率是不管的。
第二个条件:检测的项目和方法要在医保目录内。 医保报销有非常具体的“服务项目”名称和计价单位。比如,某些地区可能将“肿瘤组织基因测序”或“人类基因突变检测”列为可报销项目。但具体到“MET基因检测”这个细分项,是否单独列出,各地医保政策差异很大。你得搞清楚,医院给你开的检测单子,对应的收费项目是不是医保认可的那一个。
第三个条件:在具有资质的医疗机构进行检测。 这个检测必须在你就诊的、有相关诊疗资质的医院内完成,或者由医院委托给有资质的第三方检测机构。你自己随便找个商业检测机构做,医保是绝对不认的。
简单说,能不能报销,就是医生、病情、检测项目、医院资质这几条线要对得上。最靠谱的办法,就是直接问你主治医院的医保办公室或者住院结算处,他们给你的答复最权威。
自费要花多少钱?不同检测方法价格差在哪?
万一不符合报销条件,或者你当地医保政策暂时没覆盖,咱们就得了解一下自费的行情。MET检测不是一口价,费用差距挺大的,从一两千到上万都有可能,这主要取决于检测方法。
便宜一点的,比如免疫组化(IHC)或者荧光原位杂交(FISH),它们主要看MET蛋白过表达或者基因扩增。这些算是比较传统的技术,费用相对低一些,可能在大几千块的范围。但它们可能检测不出MET 14号外显子跳跃突变这种类型。
现在更主流、更全面的方法是基因测序。 特别是二代测序(NGS),也就是大家常说的“大Panel检测”。它一次性能测几十个甚至几百个癌症相关基因,MET基因的各种突变类型(包括关键的14跳突变)都能覆盖。这个就贵多了,通常要上万块。贵有贵的道理,它信息量最大,一次性能为后续可能的治疗方案选择提供更全面的地图。
所以,当医生建议做检测时,你不妨多问一句:“医生,咱们用哪种方法测?大概费用是多少?” 心里有个底,才好做决定。
医生,我该怎么做这个检测?流程和时机有讲究
知道了钱的事,那具体该怎么操作呢?流程其实不复杂,但时机很重要。
最好的检测标本是新鲜的肿瘤组织,比如你手术切下来的,或者穿刺活检取到的。这是金标准。所以,如果你刚做完活检或手术,记得提醒一下病理科医生,留出足够的组织样本做基因检测。万一组织样本不够或者无法获取,现在用血液(液体活检)也可以做,只是准确性可能略逊于组织,但它无创、方便,适合没法再次穿刺的患者。
什么时候该做这个检测? 对于晚期肺癌患者,确诊后、制定一线治疗方案前,就应该考虑进行包括MET在内的多基因检测了。别等到所有标准治疗都失败了才想起来,那时候可能就错过了最佳用药时机。主动和你的主治医生讨论:“我的情况,有没有必要做一下基因检测,看看有没有靶向药的机会?” 把MET检测,医保能报销吗这样的实际问题也一并提出来,好的医生会帮你一起想办法。
最后总结一下:关于MET检测报销,给你的几点实在建议
聊了这么多,咱们最后把要点拢一拢。关于“MET检测,医保能报销吗?”这个问题,你现在应该明白了,它取决于当地政策、你的具体病情和检测方式。
给你几个实在的建议:
1. 首要动作是咨询:别猜,直接去就诊医院的医保办问。带上你的诊断证明,问清楚报销条件、流程和需要准备的材料。
2. 和主治医生充分沟通:告诉他你的经济顾虑,一起商讨最必要的检测方案。是只做MET单基因检测,还是做更全面的NGS?根据你的病情阶段和家庭经济情况来定。
3. 保管好所有材料:从医生的医嘱、检测申请单,到最终的检测报告和收费票据,全部整理好。这些都是万一需要报销或后续申请援助的重要凭证。
4. 了解多方援助途径:如果医保不报,自费压力又大,可以问问医院或检测机构,有没有相关的患者援助项目、慈善赠药项目或临床试验可以参加。
治病路上,信息就是力量。搞清楚MET检测和报销的这些门道,能让你更安心、更主动地去面对治疗选择。希望这篇文章,真的能帮到你。